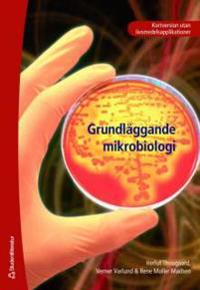

Grundläggande mikrobiologi : - kortversion (Häftad)
avHerluf Thougaard, Verner Varlund, Rene Møller Madsen
ISBN: 9789144006215 - UTGIVEN: 200710Boken ger en grundläggande förståelse för olika celltyper och deras funktion, mikroorganismer tillväxt, metabolism samt en presentation av bakteriesystematiken.
Förutom bakterier beskrivs svampar, virus, protozoer, alger och parasiter. Ett kapitel behandlar mikroorganismer hos män[...]Grundläggande mikrobiologi med livsmedelsapplikationer (Häftad)
avHerluf Thougaard, Verner Varlund, Rene Møller Madsen
ISBN: 9789144006567 - UTGIVEN: 200709Boken ger en grundläggande förståelse för olika celltyper och deras funktion, mikroorganismers tillväxt, metabolism samt en presentation av bakteriesystematiken.
Förutom bakterier beskrivs svampar, virus, protozoer, alger och parasiter. Ett kapitel behandlar mikroorganismer hos mä[...]